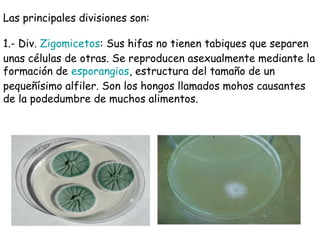
Las principales divisiones son:
1.- Div. Zigomicetos: Sus hifas no tienen tabiques que separen
unas células de otras. Se reproducen asexualmente mediante la
formación de esporangios, estructura del tamaño de un
pequeñísimo alfiler. Son los hongos llamados mohos causantes
de la podedumbre de muchos alimentos.

Este documento describe la clasificación y características de los cinco reinos biológicos. Explica que los seres vivos se clasifican en los reinos Monera, Protista, Fungi, Plantae y Animalia. Detalla algunas de las características clave, como las células procariotas o eucariotas, y los criterios usados en la clasificación como la anatomía, metabolismo y reproducción.